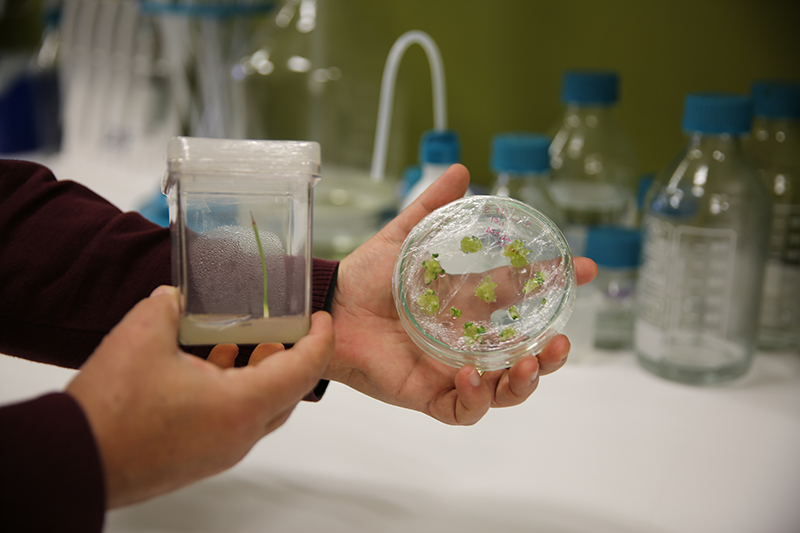

Hızlı Erişim
Haberler
Kocaeli Üniversitesi ve Assan Alüminyum Sanayi ve Ticaret A.Ş. işbirliğiyle “Biyoçeşitliliği Koruma” Projesi
Kocaeli Üniversitesi ile Assan Alüminyum Sanayi ve Ticaret A.Ş.’nin birlikte hayata geçirdikleri “Biyoçeşitliliği Koruma” projeleriyle sürdürülebilir geleceğe katkı sağlanıyor.
“Biyoçeşitliliği Koruma” projesi, Kocaeli Üniversitesi Fen Edebiyat Fakültesi Biyoloji Bölüm Başkanı Prof. Dr. Fazıl Özen ve Doç. Dr. Arda Acemi başkanlığında, Kocaeli Üniversitesi Fen Edebiyat Fakültesi Biyoloji Bölümü Bitki Doku Kültürü Ar-Ge Laboratuvarında gerçekleştirildi.
Kocaeli Üniversitesi ve Assan Alüminyum Sanayi ve Ticaret A.Ş. işbirliğiyle 2019 yılında başlatılan proje ile Dünya Doğa ve Doğal Kaynakları Koruma Birliği (IUCN)’nin sınıflandırmasına göre CR (kritik tükenme tehlikesi) kategorisinde olan ve tıbbi açıdan önemi bulunan Amsonia orientalis (Mavi Yıldız) bitkisinin çoğaltımı ve sürdürülebilir kullanımı üzerine çalışmalar gerçekleştirildi.
Projenin ikinci fazında ise yine tıbbi açıdan değeri bulunan ve Türkiye Bitkileri Kırmızı Kitabı’na göre EN (tehlikede) kategorisinde olan Pancratium maritimum (Kum Zambağı) bitkisinin çoğaltılması, ait olduğu habitata aktarılması ve popülasyonlarının güçlendirilmesi adına çalışmalar gerçekleştirildi. Bu kapsamda çok sayıda bitki üretilerek bu bitkiler koruma altında oldukları doğal yaşam alanlarına aktarıldı.
Projenin başında bulunan Kocaeli Üniversitesi Fen Edebiyat Fakültesi Biyoloji Bölüm Başkanı Prof. Dr. Fazıl Özen ve Doç. Dr. Arda Acemi, Assan Alüminyum Sanayi ve Ticaret A.Ş. ile ilerleyen zamanlarda yeni bir işbirliği planlaması yapılabileceğini duyurdular. Bitki Doku Kültürü Ar-Ge Laboratuvarında tehlike altındaki diğer bazı bitki türleri üzerine de çalışmalar yürüttüklerini belirten araştırmacılar, proje kapsamında sağlanılan imkanlardan dolayı Kocaeli Üniversitesi’ne ve Assan Alüminyum Sanayi ve Ticaret A.Ş.’ye teşekkürlerini sundular.
İLETİŞİM/ADRES
+90 (262) 303 10 43
+90 (262) 303 10 43
kouhalk@gmail.com, halk@kocaeli.edu.tr
Kocaeli Üniversitesi Umuttepe Yerleşkesi
Baki Komsuoğlu Kültür ve Kongre Merkezi
41001, İzmit/KOCAELi